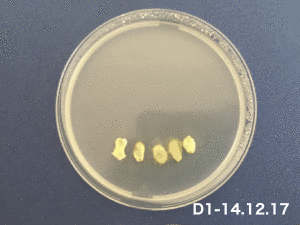

SLIME MOLDS
Color: Yellow
Size: Depending on growing
Species: Single-celled organism(belonging to the kingdom of the amoeba)
Ability: Joining together with other cells to form a mass super-cell connective net to maximise its resources
Habitat: Dark, damp and warm place(naturally foraging in woodlands)
Favorite food: Porridge oats(naturally eating rotting vegetation)
Character: Mapping its territory, knowing itself, and move with seeming intention
Intelligence support: The continuous, synchronous oscillation within the cell (A vein-like structure carrying cellular material, nutrients and chemical information through the cell, streaming first in one direction and then back in another. The continuous, synchronous oscillation within the cell.)
Motto: No Brains, No Feet, No Problem
"Achievement": Building Tokyo rail system in one day; Providing references for Artificial Intelligence.
Experiment with different medium
First try - Agar medium and paper on December
December 13th
Extracted the slime molds in three different dishes on the agar medium. One is the tube with oats randomly on the wall of the tube. The second one is the dish with a piece of cutting paper and the oats on the head. The last one is the dish with 5 oats in a line.
December 14th - December 20th Observation GIF
Summary:
1. The trails of the slime molds growing became white from yellow, also they grow so fast and I didn't document the processing of the changes. According to the observation, they moved as a group and was always in connection. For observing much more movement, I would try to change the times of observation and documents.
2.Slime molds didn't grow out of my expectation in a dispersed way. They grew towards different directions in different time (from right side to left, and back to right ), rather than spreading to all directions at the same time.
3.I tried use the tube with agar full of inside to grow slime molds. Unfortunately, slime molds were only alive around one piece of oat, and becoming sick 7days later. The difference from the living of slime molds is air.
Second try - Agar medium with mushroom 10th January-17th January
According to reference who fed the slime molds as pet, the slime molds live under the woodlands where is dark and damp and enjoy the mushroom. I tried to use mushroom to feed it and put it in the package to store. However there was no reaction from slime molds, even the mushroom was rotting. And the temperature was almost kept during 21℃-26℃.
Third try - Only agar medium and oats 17th January-24th January
References: [5]
IDEA
Growing slime molds on a face-like pattern. According to the situations they grow, it can be imagined as different hair styles or beard and so on. Also, it can be imagined people will be in different emotions (happiness, sadness ,confusing...)according to the all kinds of hair styles.